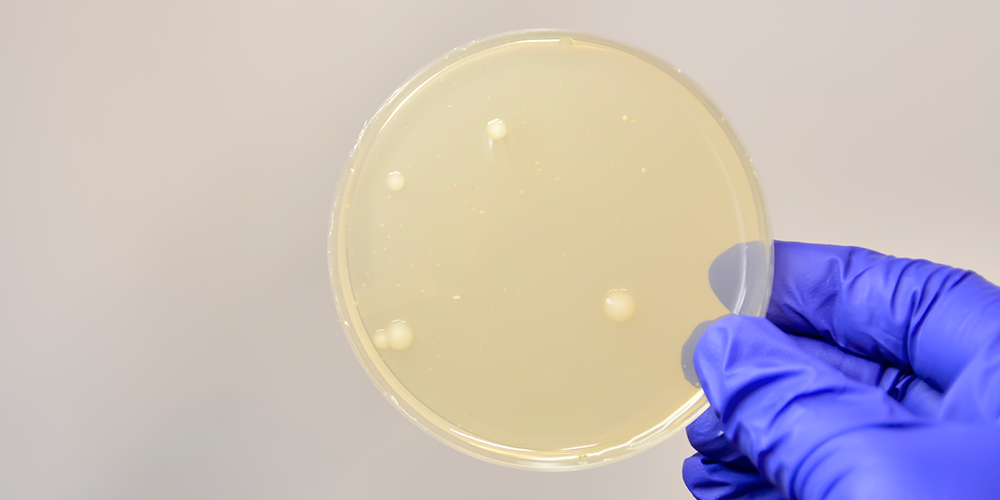

New NICE Medical Technologies Guidance announced for the use of Leukomed® Sorbact® in caesarean section and vascular surgery.
New medical technologies guidance from the UK National Institute for Health and Care Excellence (NICE) recommends that Leukomed Sorbact should be considered as an option for preventing surgical site infection (SSI) in closed surgical wounds with low to moderate exudate after caesarean section and vascular surgery.
5 clinical studies, including 3 randomised trials, were reviewed as part of the NICE guidance assessment process, which concluded that the evidence suggests that Leukomed Sorbact:
- reduces SSI in caesarean section and vascular surgery.
- may reduce antibiotic use.
- may reduce readmissions from wound complications.
- is cost-saving for caesarean section and vascular surgery
Leukomed Sorbact is an interactive dressing that binds to the microbes that cause surgical site infection so they are removed when the dressing is changed.
Evidence suggests that using Leukomed Sorbact instead of standard dressings after caesarean section and vascular surgery reduces the rate of surgical site infection and leads to cost savings.